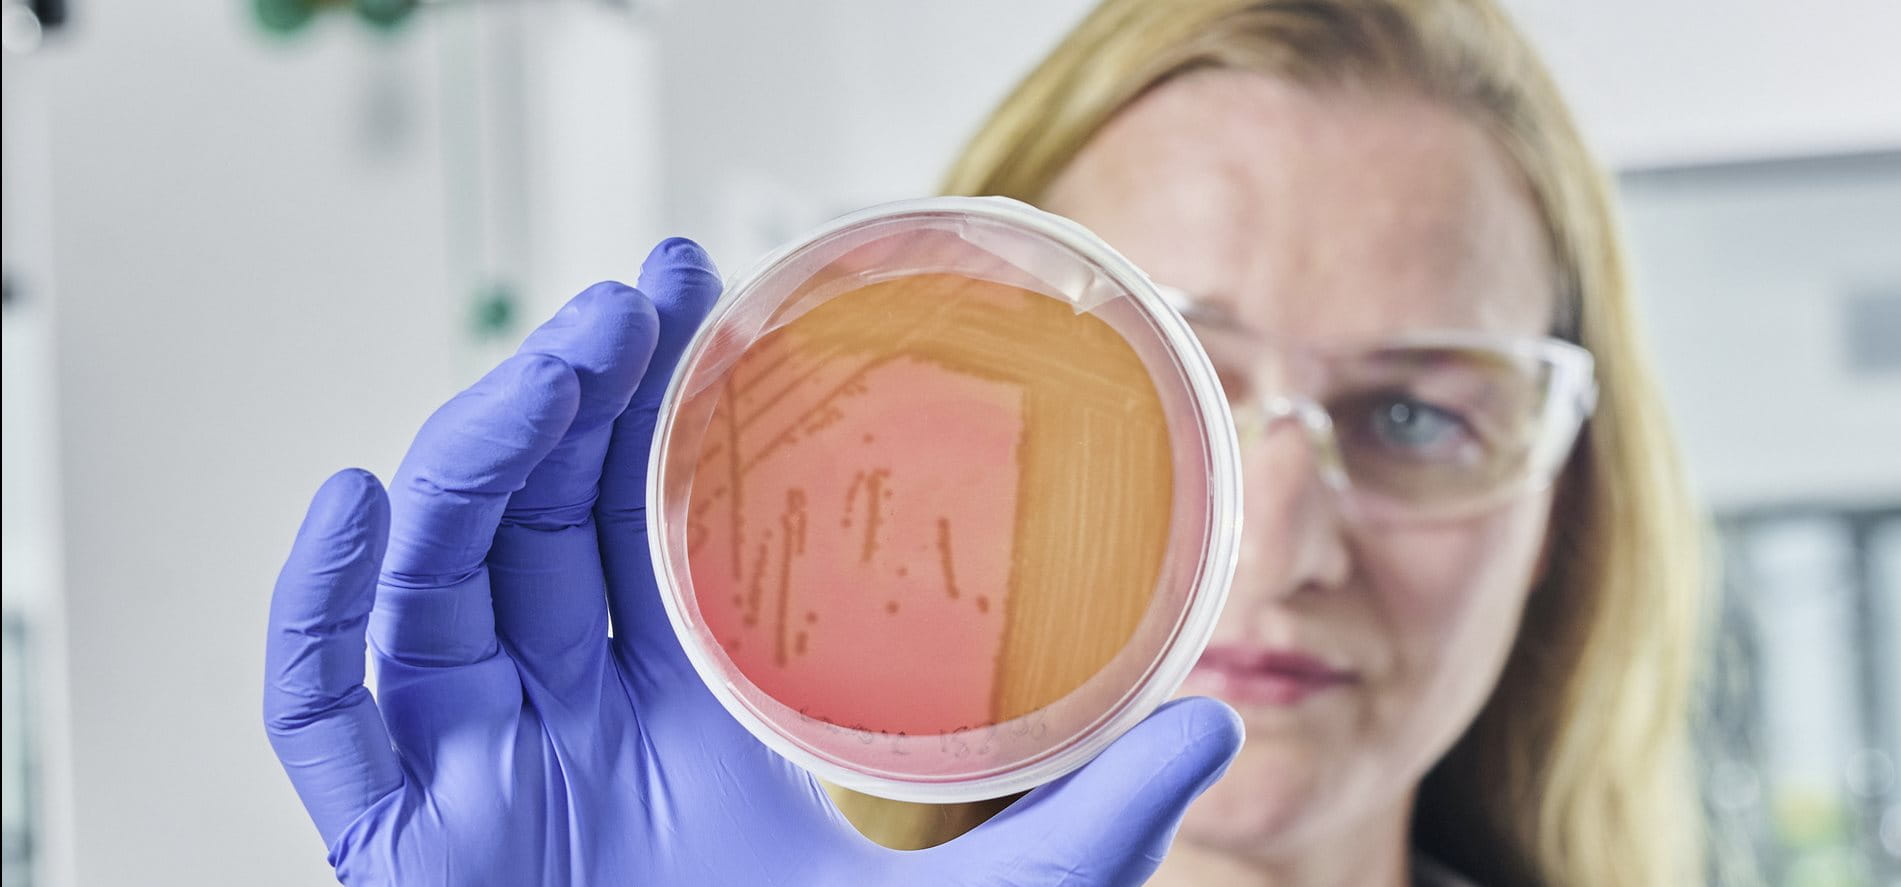

For over 140 years, Beiersdorf’s Research & Development has been unlocking the skin’s complex processes – setting significant milestones in skin research. Our multidisciplinary teams combine scientific expertise with cutting-edge technologies to create skin innovations that meet diverse needs. Driven by curiosity and collaboration, we pioneer product solutions that touch people’s lives around the world.